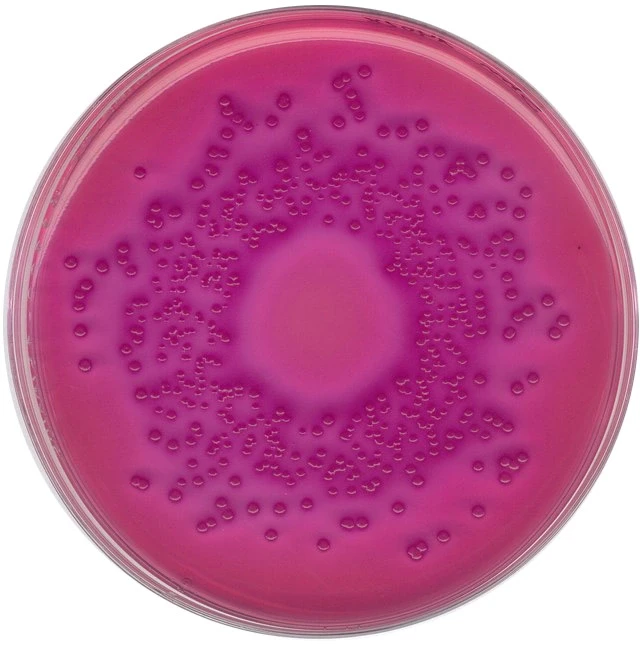

Агар с глюкозой
Агар с глюкозой 140 фотографий
Постановление правительства от 28.03 2019
Курсовые разницы в 1с в 2026
Шо ты лысый плаки плаки про кого
Полюби полюби ее опять
Изрезана ли береговая линия
Скидка на проезд на ласточке
Bob fusion
Сколько дней длилась первая смена в орленке
Отель авант пермь
Шенген в москве 2026